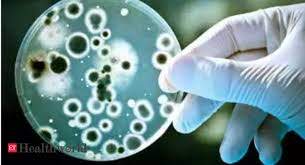

ভাইরাসের পর চীনে ব্যাকটেরিয়ার ছোবলে হাজারও লোক সংক্রামিত
কাজকেরিয়ার অনলাইন নিউজ ডেস্কঃ গত বছর চীনে একটি বায়োফার্মাসিউটিক্যাল সংস্থা থেকে ব্যাকটেরিয়া লিক হয়ে হাজারও মানুষকে সংক্রামিত করেছে। ঘটনাটির সূত্রপাত, উত্তর-পূর্ব চীনে গানসুর রাজধানী লানজহুতে। সেখানকার স্বাস্থ্য অধিকর্তা জানিয়েছে প্রায় ৩২৪৫ জন মানুষ এর ফলে ব্রুসেলোসিস রোগে আক্রান্ত হয়েছেন। সিএনএন-এর সূত্র অনুসারে, এই রোগটির জন্য দায়ী হল ব্রুসেল্লা ব্যাকটেরিয়া। সাধারণত যে সব প্রাণীরা মানুষের বিভিন্ন প্রয়োজনে গৃহপালিত পশু হিসেবে ব্যবহৃত হয়, তাদের মধ্যে এই ব্যাকটেরিয়া পাওয়া যায়। সেখানে স্বাস্থ্য অধিকর্তা সূত্রে জানা গিয়েছে, ঝংমু লানঝো জৈবিক ফার্মাসিউটিক্যাল কারখানায় গত বছরের জুলাই থেকে আগস্টের মধ্যে এই রোগ শুরু হয়েছিল। ১১ হাজার ৪০১ জন ব্যক্তি এই ব্যাকটিরিয়ায় আক্রান্ত হয়েছে বলে জানা গিয়েছে । এই শহরের মোট জনসংখ্যা ২৯ লক্ষের মধ্যে এখন পর্যন্ত মোট ২১ হাজার ৮৪৭ জন ব্যক্তিকে পরীক্ষা করা হয়েছে।
এই রোগের নাম মাল্টা বা ভূমধ্যসাগরীয় জ্বর। রোগের লক্ষণগুলির মধ্যে রয়েছে জ্বর, মাথাব্যথা, পেশী ব্যথা, দুর্বলতা ইত্যাদি। এর মধ্যে কিছু সমস্যা গুরুতর রূপ নিতে পারে এবং কখনও ঠিক নাও হতে পারে, যেমন বাত বা কিছু অঙ্গপ্রত্যঙ্গের ফোলাভাব। আমেরিকা যুক্তরাষ্ট্রের রোগ নিয়ন্ত্রণ ও প্রতিরোধকের (সিডিসি) মতে, মানুষের সাথে পারস্পরিক সম্পর্কের কারণে এই রোগের সংক্রমণ হয় না, তবে সংক্রামিত খাবার, জল বা শ্বাসের মাধ্যমে ছড়িয়ে পড়তে পারে। জানা যায় যে, ব্রুসেলা ভ্যাকসিন তৈরির প্রক্রিয়ায় মেয়াদোত্তীর্ণ স্যানিটাইজার ব্যবহৃত করা হয়েছে। উল্লেখযোগ্য যে, বিশ্বব্যাপী মহামারী কোভিড-১৯ এর প্রথম ঘটনাটি চীনেই ঘটেছিল। গত বছরের শেষের দিকে উহানের সামুদ্রিক খাদ্য বাজার থেকে নির্গত করোনার ভাইরাসের কারণে পুরো বিশ্ব সংক্রামিত হয়েছে।

